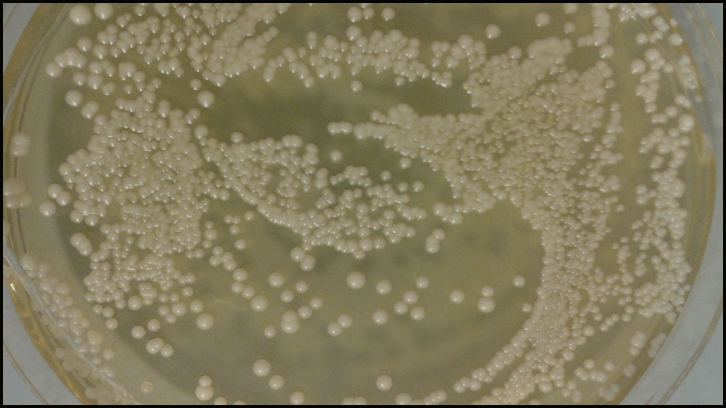
aroma a frutas a partir de resíduos orgánicos

Les experiències d’estrès a la infància no afecten per igual mascles i femelles
L’estrès infantil ens prepara, en determinades circumstàncies, per a situacions futures, però podria no fer-ho de la mateixa manera en homes i en dones. Científics de l’Institut de...